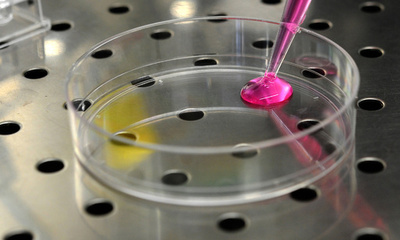
女性のがん遺伝子検査、受診機会失われる傾向に 米調査

遺伝性聴覚障害、治療でささやき声も聞こえるように マウス実験
このニュースをシェア

【2月8日 AFP】聴覚障害がある実験用マウスが良性のウイルスを使った遺伝子治療によって聴力を得られるようになったとする2つの研究論文が6日、英科学誌「ネイチャー・バイオテクノロジー(Nature Biotechnology)」で発表された。遺伝性の聴覚障害者の治療に道を開く可能性があると期待されている。
世界保健機関(WHO)によれば、遺伝性の聴覚障害のある人は世界で約1億2500万人とされる。
米ハーバード大医学部(Harvard Medical School)のコンスタンティーナ・スタンコビッチ(Konstantina Stankovic)教授らが行った1つ目の研究では、特定の遺伝性聴覚障害を治すことのできる遺伝子を、良性ウイルスを使ってマウスの内耳まで運んだ。それまでの同様の研究では失敗が繰り返されていたが、今回はウイルスを「正しい場所」に届けることに成功。内耳で音波を調整する働きをする「外有毛細胞」に注入することができた。
この技術によって「これまで達成できなかったレベルまで」聴力と平衡感覚を回復させることができ、「マウスは人間のささやく声が聞こえるようになった」と、米ボストン子ども病院(Boston Children's Hospital)FMカービー神経生物学センター(F.M. Kirby Neurobiology Center)の研究者グウェネル・ゲリオック(Gwenaelle Geleoc)氏は声明で述べている。
ゲリオック氏が主導した2つ目の研究では、アッシャー症候群の突然変異遺伝子を持つマウスに対し、同じようにウイルスを使った治療を試みた。アッシャー症候群は主に子どもが発症する遺伝性の希少疾患で、聴覚障害や平衡感覚異常、時に失明まで引き起こす。
生まれた直後のアッシャー症候群のマウスに対し、異常がある内耳の有毛細胞に正常型の遺伝子をウイルスを使って運んだところ、これまでにない大きな成果が得られ、治療したマウス25匹中19匹が80デシベル(dB)より小さい音が聞こえるようになった。人の通常の話し声の大きさは約70dBといわれている。
研究に参加していない専門家は今回の成果を「非常に励みになる」と評価する一方、この治療法の安全性はまだ確認されておらず、臨床試験は何年も先になるだろうと指摘した。(c)AFP/Marlowe HOOD